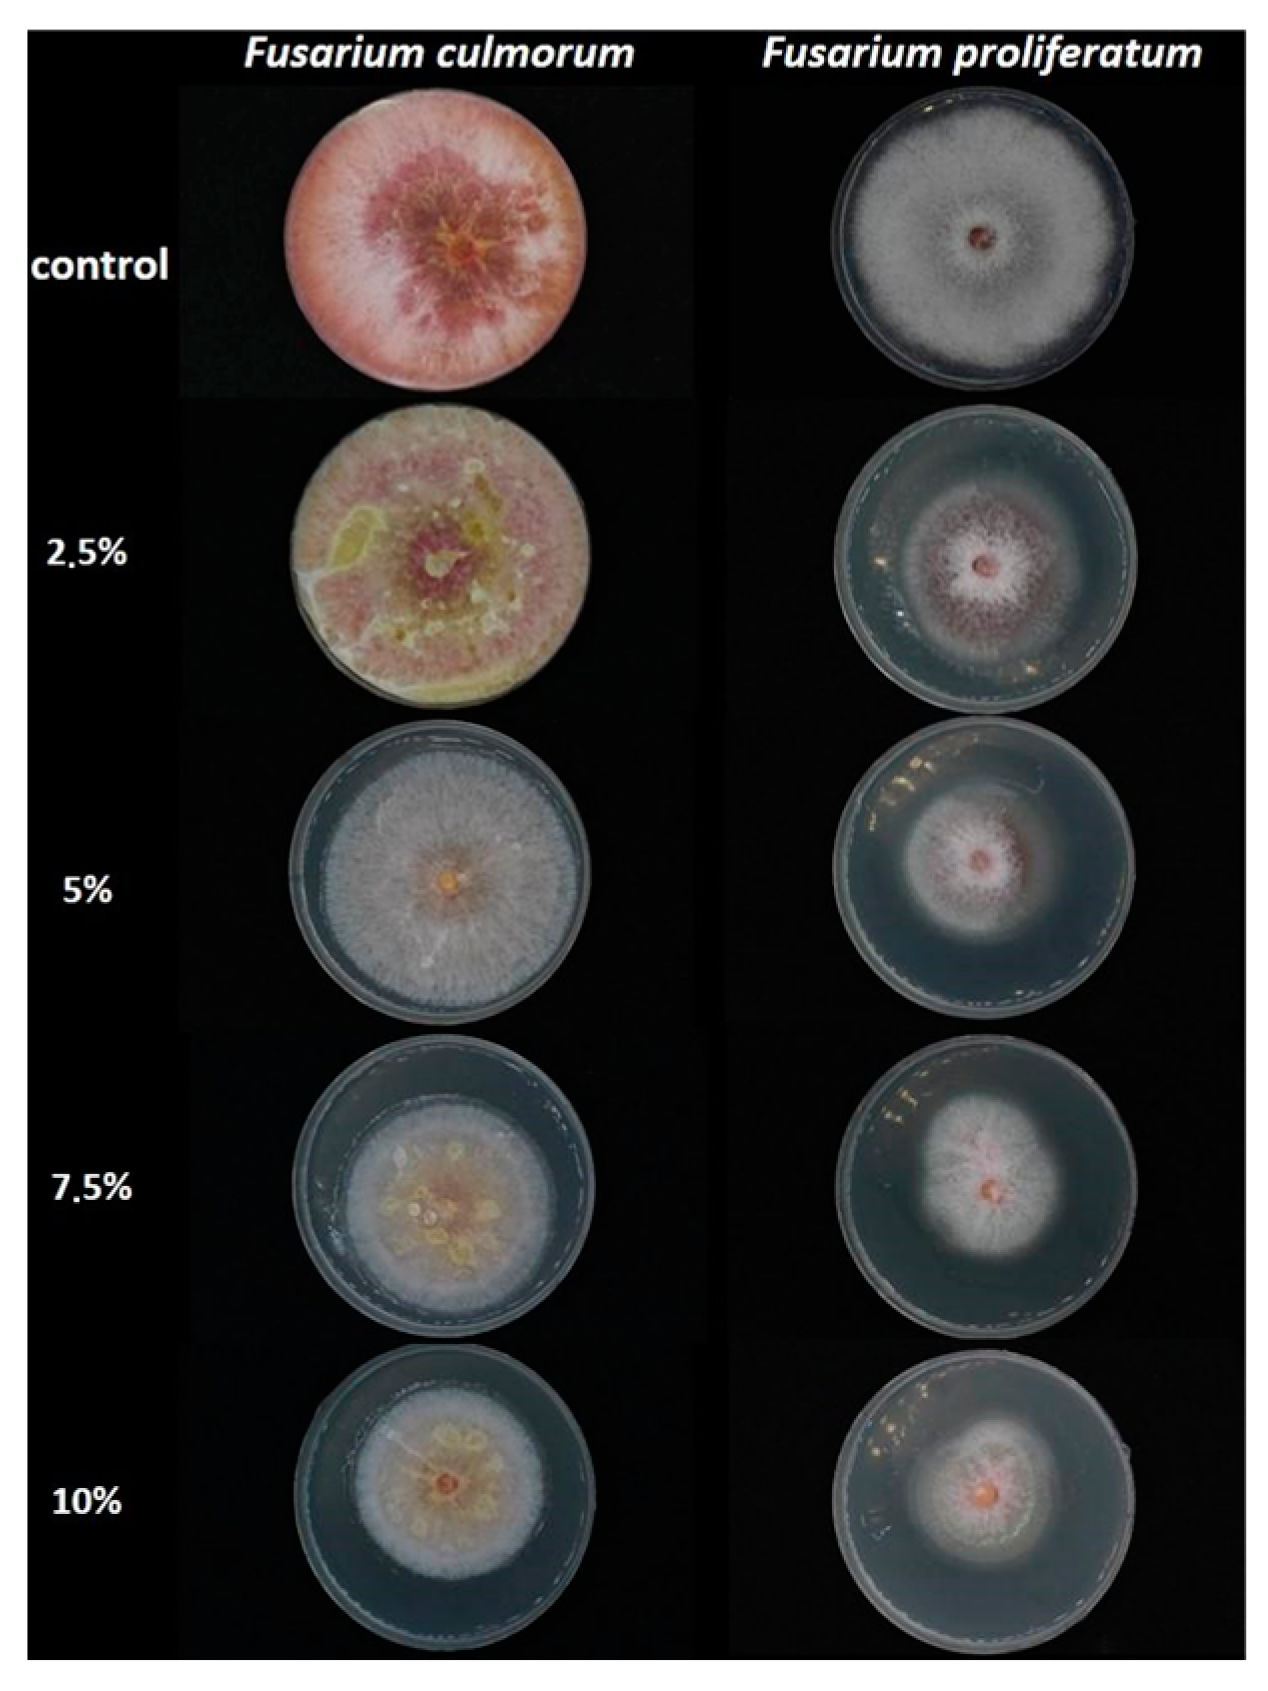

Lamium album Flower Extracts: A Novel Approach for Controlling Fusarium Growth and Mycotoxin Biosynthesis
Abstract
:1. Introduction
2. Results
2.1. Inhibitory Effect of L. album Flower Extract against Fusarium culmorum and F. proliferatum
2.2. The Antifungal Effects of L. album Flower Extract on the Ergosterol Content
2.3. The Effects of L. album Flower Extract on Mycotoxin Biosynthesis
3. Discussion
4. Conclusions
5. Materials and Methods
5.1. Chemicals
5.2. Plant Material
5.3. Lamium album Flower Extraction
5.4. Description of Fungal Test Pathogens
5.5. Determination of the Antifungal Activity of L. album Flower Extracts
5.6. Determination of ERG Content
5.7. Determination of Mycotoxins by Using UPLC/MS/MS
5.8. Statistical Analysis
Supplementary Materials
Author Contributions
Funding
Institutional Review Board Statement
Informed Consent Statement
Data Availability Statement
Acknowledgments
Conflicts of Interest
References
- Peng, Y.; Li, S.J.; Yan, J.; Tang, Y.; Cheng, J.P.; Gao, A.J.; Yao, X.; Ruan, J.J.; Xu, B.L. Research Progress on Phytopathogenic Fungi and Their Role as Biocontrol Agents. Front. Microbiol. 2021, 12, 1209. [Google Scholar] [CrossRef] [PubMed]
- Abdallah, F.M.; Ameye, M.; De Saeger, S.; Audenaert, K.; Haesaert, G. Biological Control of Mycotoxigenic Fungi and Their Toxins: An Update for the Pre-Harvest Approach. In Mycotoxins—Impact and Management Strategies; IntechOpen: London, UK, 2019; pp. 59–89. [Google Scholar] [CrossRef]
- Ferrigo, D.; Raiola, A.; Causin, R. Fusarium Toxins in Cereals: Occurrence, Legislation, Factors Promoting the Appearance and Their Management. Molecules 2016, 21, 627. [Google Scholar] [CrossRef] [PubMed]
- Okorski, A.; Milewska, A.; Pszczółkowska, A.; Karpiesiuk, K.; Kozera, W.; Dąbrowska, J.A.; Radwińska, J. Prevalence of Fusarium Fungi and Deoxynivalenol Levels in Winter Wheat Grain in Different Climatic Regions of Poland. Toxins 2022, 14, 102. [Google Scholar] [CrossRef] [PubMed]
- Wiśniewska, H.; Stępień, Ł.; Waśkiewicz, A.; Beszterda, M.; Góral, T.; Belter, J. Toxigenic Fusarium Species Infecting Wheat Heads in Poland. Cent. Eur. J. Biol. 2014, 9, 163–172. [Google Scholar] [CrossRef]
- Liu, L.; Xie, M.; Wei, D. Biological Detoxification of Mycotoxins: Current Status and Future Advances. Int. J. Mol. Sci. 2022, 23, 1064. [Google Scholar] [CrossRef]
- Puri, S.; Shingh, S.; Tiwari, P. Mycotoxins: A Threat to Food Security and Health. Int. J. Appl. Sci. Biotechnol. 2019, 7, 298–303. [Google Scholar] [CrossRef]
- Awuchi, C.G.; Ondari, E.N.; Ogbonna, C.U.; Upadhyay, A.K.; Baran, K.; Okpala, C.O.R.; Korzeniowska, M.; Guiné, R.P.F. Mycotoxins Affecting Animals, Foods, Humans, and Plants: Types, Occurrence, Toxicities, Action Mechanisms, Prevention, and Detoxification Strategies—A Revisit. Foods 2021, 10, 1279. [Google Scholar] [CrossRef]
- Mielniczuk, E.Z.; Skwaryło-Bednarz, B. Fusarium Head Blight, Mycotoxins and Strategies for Their Reduction. Agronomy 2020, 10, 509. [Google Scholar] [CrossRef]
- Uwineza, P.A.; Urbaniak, M.; Bryła, M.; Stępień, Ł.; Modrzewska, M.; Waśkiewicz, A. In Vitro Effects of Lemon Balm Extracts in Reducing the Growth and Mycotoxins Biosynthesis of Fusarium culmorum and F. proliferatum. Toxins 2022, 14, 355. [Google Scholar] [CrossRef]
- Alisaac, E.; Mahlein, A.-K.; Alisaac, E.; Mahlein, A.-K. Fusarium Head Blight on Wheat: Biology, Modern Detection and Diagnosis, and Integrated Disease Management. Toxins 2023, 15, 192. [Google Scholar] [CrossRef]
- Jafarzadeh, S.; Abdolmaleki, K.; Javanmardi, F.; Hadidi, M.; Mousavi Khaneghah, A. Recent Advances in Plant-Based Compounds for Mitigation of Mycotoxin Contamination in Food Products: Current Status, Challenges and Perspectives. Int. J. Food Sci. Technol. 2022, 57, 2159–2170. [Google Scholar] [CrossRef]
- Marc, R.A.; Marc, R.A. Implications of Mycotoxins in Food Safety. Mycotoxins Food Saf.-Recent Adv. 2022. [Google Scholar] [CrossRef]
- Udomkun, P.; Wiredu, A.N.; Nagle, M.; Müller, J.; Vanlauwe, B.; Bandyopadhyay, R. Innovative Technologies to Manage Aflatoxins in Foods and Feeds and the Profitability of Application—A Review. Food Control 2017, 76, 127–138. [Google Scholar] [CrossRef]
- Makhuvele, R.; Naidu, K.; Gbashi, S.; Thipe, V.C.; Adebo, O.A.; Njobeh, P.B. The Use of Plant Extracts and Their Phytochemicals for Control of Toxigenic Fungi and Mycotoxins. Heliyon 2020, 6, e05291. [Google Scholar] [CrossRef] [PubMed]
- Shuping, D.S.S.; Eloff, J.N. The Use of Plants to Protect Plants and Food against Fungal Pathogens: A review. Afr. J. Tradit. Complement. Altern. Med. 2017, 14, 120–127. [Google Scholar] [CrossRef] [PubMed]
- Chulze, S.N.; Palazzini, J.M.; Torres, A.M.; Barros, G.; Ponsone, M.L.; Geisen, R.; Schmidt-Heydt, M.; Köhl, J. Biological Control as a Strategy to Reduce the Impact of Mycotoxins in Peanuts, Grapes, and Cereals in Argentina. Food Addit. Contam. 2014, 32, 471–479. [Google Scholar] [CrossRef]
- Mirza Alizadeh, A.; Golzan, S.A.; Mahdavi, A.; Dakhili, S.; Torki, Z.; Hosseini, H. Recent Advances on the Efficacy of Essential Oils on Mycotoxin Secretion and Their Mode of Action. Crit. Rev. Food Sci. Nutr. 2022, 62, 4726–4751. [Google Scholar] [CrossRef]
- Lengai, G.M.W.; Muthomi, J.W.; Mbega, E.R. Phytochemical Activity and Role of Botanical Pesticides in Pest Management for Sustainable Agricultural Crop Production. Sci. Afr. 2020, 7, e00239. [Google Scholar] [CrossRef]
- Yordanova, Z.P.; Zhiponova, M.K.; Iakimova, E.T.; Dimitrova, M.A.; Kapchina-Toteva, V.M. Revealing the Reviving Secret of the White Dead Nettle (Lamium album L.). Phytochem. Rev. 2014, 13, 375–389. [Google Scholar] [CrossRef]
- Pereira, O.R.; Domingues, M.R.M.; Silva, A.M.S.; Cardoso, S.M. Phenolic Constituents of Lamium album: Focus on Isoscutellarein Derivatives. Food Res. Int. 2012, 48, 330–335. [Google Scholar] [CrossRef]
- Todorov, D.; Dimitrova, M.; Shishkova, K.; Yordanova, Z.; Kapchina-Toteva, V.; Shishkov, S. Comparative Anti-Herpes Effects of the Chloroform In Vitro and In Vivo Extracts, Derived from Lamium album L. Agric. Acad. 2013, 19, 190–193. [Google Scholar]
- Chipeva, V.A.; Petrova, D.C.; Geneva, M.E.; Dimitrova, M.A.; Moncheva, A.P.; Kapchina-Toteva, V.M. Antimicrobial Activity of Extracts from In Vivo and In Vitro Propagated Lamium album L. Plants. Afr. J. Tradit. Complement. Altern. Med. 2013, 10, 559–562. [Google Scholar] [CrossRef] [PubMed]
- Czerwińska, M.E.; Kalinowska, E.; Popowski, D.; Bazylko, A. Lamalbid, Chlorogenic Acid, and Verbascoside as Tools for Standardization of Lamium album Flowers-Development and Validation of HPLC-DAD Method. Molecules 2020, 25, 1721. [Google Scholar] [CrossRef]
- Moskova-Doumanova, V.; Miteva, G.; Dimitrova, M.; Topouzova-Hristova, T.; Kapchina, V. Methanol and Chloroform Extracts from Lamium album L. Affect Cell Properties of A549 Cancer Lung Cell Line. Biotechnol. Biotechnol. Equip. 2012, 26, 120–125. [Google Scholar] [CrossRef]
- Uwineza, P.A.; Gramza-Michałowska, A.; Bryła, M.; Waśkiewicz, A. Antioxidant Activity and Bioactive Compounds of Lamium album Flower Extracts Obtained by Supercritical Fluid Extraction. Appl. Sci. 2021, 11, 7419. [Google Scholar] [CrossRef]
- Shah, T.; Khan, F.; Bule, M.; Niaz, K. White Dead-Nettle (Lamium album). In Nonvitamin and Nonmineral Nutritional Supplements; Academic Press: Cambridge, MA, USA, 2019; Volume 8, pp. 455–459. [Google Scholar] [CrossRef]
- Paduch, R.; Wojciak, K.M.; Matysik, G. Investigation of Biological Activity of Lamii Albi Flos Extracts. J. Ethnopharmacol. 2007, 110, 69–75. [Google Scholar] [CrossRef] [PubMed]
- Pourmirzaee, T.; Kelayeh, S.; Abedinzade, M.; Ghorbani, A. A Review on Biological Effects of Lamium album (White Dead Nettle) and Its Components. J. Herbmed Pharmacol. 2019, 8, 185–193. [Google Scholar] [CrossRef]
- García-Ramírez, E.; Contreras-Oliva, A.; Salinas-Ruiz, J.; Hernández-Ramírez, G.; Spinoso-Castillo, J.L.; Cuevas, S.I.C. Plant Extracts Control In Vitro Growth of Disease-Causing Fungi in Chayote. Plants 2023, 12, 1800. [Google Scholar] [CrossRef]
- Reyes-Vaquero, L.; Bueno, M.; Ventura-Aguilar, I.R.; Aguilar-Guadarrama, B.; Robledo, N.; Sepúlveda-Jiménez, G.; Vanegas-Espinoza, E.P.; Ibáñez, E.; Del Villar-Martínez, A.A. Seasonal Variation of Chemical Profile of Ruta graveolens extracts and biological activity against Fusarium oxysporum, Fusarium proliferatum and Stemphylium vesicarium. Biochem. Syst. Ecol. 2021, 95, 104223. [Google Scholar] [CrossRef]
- Ngegba, P.M.; Kanneh, S.M.; Bayon, M.S.; Ndoko, E.J.; Musa, P.D. Fungicidal Effect of Three Plants Extracts in Control of Four Phytopathogenic Fungi of Tomato (Lycopersicum esculentum L.) Fruit Rot. Int. J. Environ. Agric. Biotechnol. 2018, 3, 112–117. [Google Scholar] [CrossRef]
- Hassan, H.S.; Mohamed, A.A.; Feleafel, M.N.; Salem, M.Z.M.; Ali, H.M.; Akrami, M.; Abd-Elkader, D.Y. Natural Plant Extracts, and Microbial Antagonists to Control Fungal Pathogens and Improve the Productivity of Zucchini (Cucurbita pepo L.) In Vitro and Greenhouse. Horticulturae 2021, 7, 470. [Google Scholar] [CrossRef]
- Kursa, W.; Jamiołkowska, A.; Wyrostek, J.; Kowalski, R. Antifungal Effect of Plant Extracts on the Growth of the Cereal Pathogen Fusarium Spp.—An In Vitro Study. Agronomy 2022, 12, 3204. [Google Scholar] [CrossRef]
- Bodoira, R.; Velez, A.; Maestri, D.; Herrera, J. Bioactive Compounds Obtained from Oilseed By-Products with Subcritical Fluids: Effects on Fusarium verticillioides Growth. Waste Biomass Valorization 2020, 11, 5913–5924. [Google Scholar] [CrossRef]
- Mahlo, S.M.; Chauke, H.R.; McGaw, L.; Eloff, J. Antioxidant and Antifungal Activity of Selected Medicinal Plant Extracts against Phytopathogenic Fungi. Afr. J. Tradit. Complement. Altern. Med. 2016, 13, 216–222. [Google Scholar] [CrossRef] [PubMed]
- Kalagatur, N.K.; Mudili, V.; Siddaiah, C.; Gupta, V.K.; Natarajan, G.; Sreepathi, M.H.; Vardhan, B.H.; Putcha, V.L.R. Antagonistic Activity of Ocimum sanctum L. Essential Oil on Growth and Zearalenone Production by Fusarium graminearum in Maize Grains. Front. Microbiol. 2015, 6, 892. [Google Scholar] [CrossRef]
- Ferreira, F.M.D.; Hirooka, E.Y.; Ferreira, F.D.; Silva, M.V.; Mossini, S.A.G.; Machinski, M. Effect of Zingiber officinale Roscoe Essential Oil in Fungus Control and Deoxynivalenol Production of Fusarium graminearum Schwabe in Vitro. Food Addit. Contam. Part A 2018, 35, 2168–2174. [Google Scholar] [CrossRef]
- Ferrochio, L.; Cendoya, E.; Farnochi, M.C.; Massad, W.; Ramirez, M.L. Evaluation of Ability of Ferulic Acid to Control Growth and Fumonisin Production of Fusarium verticillioides and Fusarium proliferatum on Maize Based Media. Int. J. Food Microbiol. 2013, 167, 215–220. [Google Scholar] [CrossRef]
- Heidtmann-Bemvenuti, R.; Tralamazza, S.M.; Jorge Ferreira, C.F.; Corrêa, B.; Badiale-Furlong, E. Effect of Natural Compounds on Fusarium graminearum Complex. J. Sci. Food Agric. 2016, 96, 3998–4008. [Google Scholar] [CrossRef]
- Abhishek, R.U.; Thippeswamy, S.; Manjunath, K.; Mohana, D.C. Antifungal and Antimycotoxigenic Potency of Solanum torvum Swartz. Leaf Extract: Isolation and Identification of Compound Active against Mycotoxigenic Strains of Aspergillus flavus and Fusarium verticillioides. J. Appl. Microbiol. 2015, 119, 1624–1636. [Google Scholar] [CrossRef]
- Czerwińska, M.E.; Świerczewska, A.; Granica, S. Bioactive Constituents of Lamium album L. as Inhibitors of Cytokine Secretion in Human Neutrophils. Molecules 2018, 23, 2770. [Google Scholar] [CrossRef]
- Chen, C.; Long, L.; Zhang, F.; Chen, Q.; Chen, C.; Yu, X.; Liu, Q.; Bao, J.; Long, Z. Antifungal Activity, Main Active Components and Mechanism of Curcuma Longa Extract against Fusarium graminearum. PLoS ONE 2018, 13, e0194284. [Google Scholar] [CrossRef] [PubMed]
- Salhi, N.; Mohammed Saghir, S.A.; Terzi, V.; Brahmi, I.; Ghedairi, N.; Bissati, S. Antifungal Activity of Aqueous Extracts of Some Dominant Algerian Medicinal Plants. BioMed Res. Int. 2017, 2017, 7526291. [Google Scholar] [CrossRef] [PubMed]
- Barral, B.; Chillet, M.; Doizy, A.; Grassi, M.; Ragot, L.; Léchaudel, M.; Durand, N.; Rose, L.J.; Viljoen, A.; Schorr-Galindo, S. Diversity and Toxigenicity of Fungi That Cause Pineapple Fruitlet Core Rot. Toxins 2020, 12, 339. [Google Scholar] [CrossRef]
- Wu, Q.; Patocka, J.; Nepovimova, E.; Kuca, K.A. Review on the Synthesis and a Review on the Synthesis and Bioactivity Aspects of Beauvericin, a Fusarium Mycotoxin. Front. Pharmacol. 2018, 9, 1338. [Google Scholar] [CrossRef]
- Svingen, T.; Lund Hansen, N.; Taxvig, C.; Vinggaard, A.M.; Jensen, U.; Have Rasmussen, P. Enniatin B and Beauvericin Are Common in Danish Cereals and Show High Hepatotoxicity on a High-Content Imaging Platform. Environ. Toxicol. 2017, 32, 1658–1664. [Google Scholar] [CrossRef] [PubMed]
- Bryła, M.; Waśkiewicz, A.; Ksieniewicz-Woźniak, E.; Szymczyk, K. Molecules Modified Fusarium Mycotoxins in Cereals and Their Products-Metabolism, Occurrence, and Toxicity: An Updated Review. Molecules 2018, 23, 963. [Google Scholar] [CrossRef]
- Bryła, M.; Ksieniewicz-Woźniak, E.; Waśkiewicz, A.; Yoshinari, T.; Szymczyk, K.; Podolska, G.; Gwiazdowski, R.; Kubiak, K. Transformations of Selected Fusarium Toxins and Their Modified Forms during Malt Loaf Production. Toxins 2020, 12, 385. [Google Scholar] [CrossRef]
- Perincherry, L.; Witaszak, N.; Urbaniak, M.; Waśkiewicz, A.; Stępień, Ł. Effects of Secondary Metabolites from Pea on Fusarium Growth and Mycotoxin Biosynthesis. J. Fungi 2021, 7, 1004. [Google Scholar] [CrossRef]
- Gakuubi, M.M.; Maina, A.W.; Wagacha, J.M. Antifungal Activity of Essential Oil of Eucalyptus camaldulensis Dehnh. against Selected Fusarium spp. Int. J. Microbiol. 2017, 2017, 8761610. [Google Scholar] [CrossRef]

| Extract Concentration (%) | Mycelium Growth Inhibition (%) | |
|---|---|---|
| F. culmorum | F. proliferatum | |
| Control without extracts | - | - |
| 2.5 | 0.00 a | 27.71 ± 6.26 b |
| 5 | 0.00 a | 40.16 ± 0.70 a |
| 7.5 | 23.53 ± 2.04 b | 40.56 ± 0.70 a |
| 10 | 30.59 ± 2.04 c | 42.97 ± 0.70 a |
| Extract Concentration (%) | ERG Concentration (µg/g) and Percentage of Reduction (%) | |||
|---|---|---|---|---|
| F. culmorum | F. proliferatum | |||
| (µg/g) | (%) | (µg/g) | (%) | |
| Control (without extracts) | 5036.19 ± 1178.93 c | - | 20,234.01 ± 1484.40 d | - |
| 2.5 | 3818.97 ± 829.56 bc | 24.17 c | 7778.33 ± 227.47 c | 61.56 c |
| 5 | 1864.53 ± 706.63 ab | 62.98 a | 4278.58 ± 281.07 b | 78.85 b |
| 7.5 | 1016.00 ± 200.36 a | 79.83 ab | 1549.54 ± 157.36 a | 92.34 a |
| 10 | 560.59 ± 140.09 a | 88.87 b | 1381.55 ± 191.88 a | 93.17 a |
| Plant Material | Extraction Method | Conc * | Antifungal Assay | Fusarium spp. | Inhibitory (%) | Ref. * |
|---|---|---|---|---|---|---|
| Ruta graveolens | Solid–liquid method ethanol:water (85:15 v/v) | 16 mg/mL | Agar dilution method | F. oxysporum | 72.90 | [31] |
| F. proliferatum | 68.73 | |||||
| Azadirachta indica | Distilled water | 100 mg/mL | - | F. oxysporum | 87.40 | [32] |
| Tithonia diversifolia | 76.80 | |||||
| Chromolaena odorata | 62.70 | |||||
| Eucalyptus camaldulensis leaves | Distilled water | 4 mg/mL | Agar dilution method | F. solani | 78.58 | [33] |
| F. oxysporum | 77.80 | |||||
| Salvia officinalis leaves | Reflux condenser (70% ethanol) | 20% | Poisoned method | F. avenaceum | 61.30 | [34] |
| F. culmorum | 52.59 | |||||
| F. graminearum | 38.39 | |||||
| Solanum torvum leaves | Solvent extraction (chloroform) | 1 mg/mL | Poisoned food technique | F. verticillioides | 76.42 | [41] |
| F. oxysporum | 68.00 |
Disclaimer/Publisher’s Note: The statements, opinions and data contained in all publications are solely those of the individual author(s) and contributor(s) and not of MDPI and/or the editor(s). MDPI and/or the editor(s) disclaim responsibility for any injury to people or property resulting from any ideas, methods, instructions or products referred to in the content. |
© 2023 by the authors. Licensee MDPI, Basel, Switzerland. This article is an open access article distributed under the terms and conditions of the Creative Commons Attribution (CC BY) license (https://creativecommons.org/licenses/by/4.0/).
Share and Cite
Uwineza, P.A.; Urbaniak, M.; Stępień, Ł.; Gramza-Michałowska, A.; Waśkiewicz, A. Lamium album Flower Extracts: A Novel Approach for Controlling Fusarium Growth and Mycotoxin Biosynthesis. Toxins 2023, 15, 651. https://doi.org/10.3390/toxins15110651
Uwineza PA, Urbaniak M, Stępień Ł, Gramza-Michałowska A, Waśkiewicz A. Lamium album Flower Extracts: A Novel Approach for Controlling Fusarium Growth and Mycotoxin Biosynthesis. Toxins. 2023; 15(11):651. https://doi.org/10.3390/toxins15110651
Chicago/Turabian StyleUwineza, Pascaline Aimee, Monika Urbaniak, Łukasz Stępień, Anna Gramza-Michałowska, and Agnieszka Waśkiewicz. 2023. "Lamium album Flower Extracts: A Novel Approach for Controlling Fusarium Growth and Mycotoxin Biosynthesis" Toxins 15, no. 11: 651. https://doi.org/10.3390/toxins15110651
APA StyleUwineza, P. A., Urbaniak, M., Stępień, Ł., Gramza-Michałowska, A., & Waśkiewicz, A. (2023). Lamium album Flower Extracts: A Novel Approach for Controlling Fusarium Growth and Mycotoxin Biosynthesis. Toxins, 15(11), 651. https://doi.org/10.3390/toxins15110651

